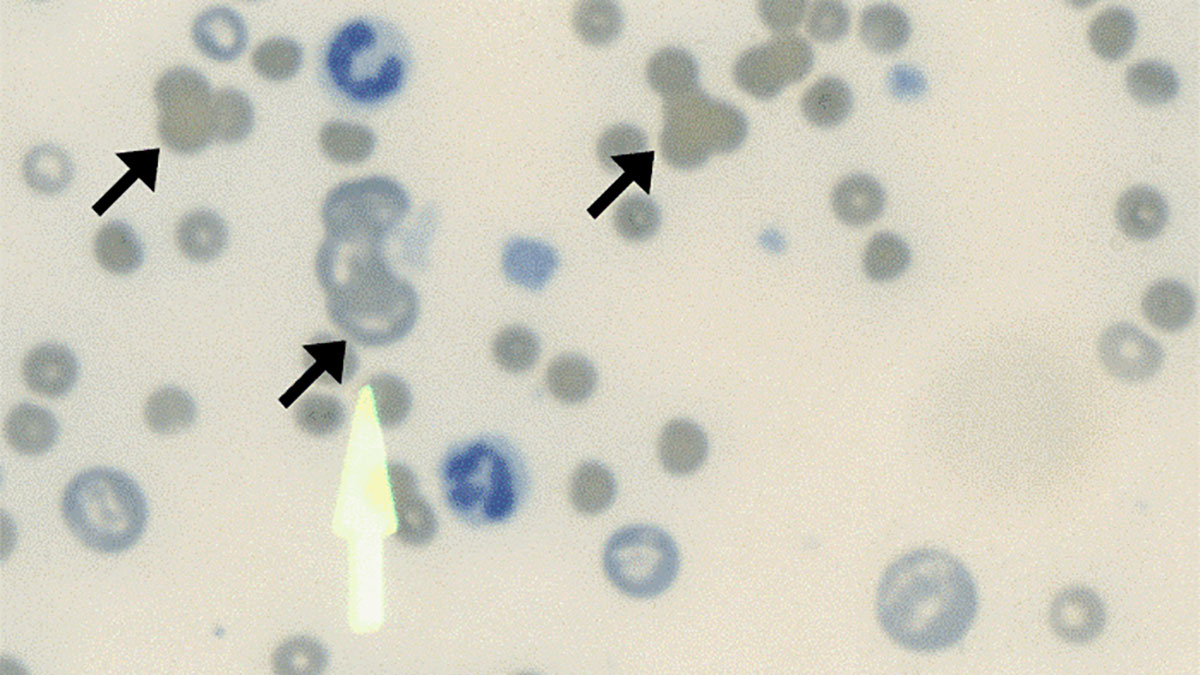
آگلوتیناسیون

تفاوت آگلوتیناسیون و رسوبگذاری ، راهنمای کامل با مثالها
در دنیای آزمایشگاه و تشخیصهای بالینی، واکنشهای آنتیژن–آنتیبادی نقش بسیار مهمی در شناسایی عوامل بیماریزا و بررسی وضعیت ایمنی بدن دارند. دو فرآیند کلیدی در این زمینه، آگلوتیناسیون و رسوبگذاری هستند که هر کدام مکانیزمها، کاربردها و شرایط ویژه خود را دارند. فهم دقیق تفاوت آگلوتیناسیون و رسوبگذاری ، انتخاب روش مناسب برای آزمایشهای تشخیصی و درک نتایج آنها را آسانتر میکند.
در این مقاله قصد داریم ابتدا مفهوم آگلوتیناسیون و نحوه عملکرد آن را بررسی کنیم، سپس انواع کاربردهای آن در تشخیصهای پزشکی و آزمایشگاهی را معرفی کنیم. علاوه بر این، تکنیکهای پیشرفتهای مانند آگلوتیناسیون-PCR را نیز توضیح خواهیم داد تا خواننده با جدیدترین روشهای تشخیصی مبتنی بر این واکنش آشنا شود. در نهایت، با ارائه مثالها و نکات کلیدی، تفاوتهای آگلوتیناسیون و رسوبگذاری را روشن کرده و کاربردهای عملی آنها را به صورت جامع نشان خواهیم داد. پس با ما همراه باشید.
آگلوتیناسیون و اصول آن
پیش از بررسی تفاوت آگلوتیناسیون و رسوبگذاری ابتدا باید با اصول این دو فرایند آشنا شویم.
آگلوتیناسیون (Agglutination) فرآیند تجمع یا کلوخهشدن آنتیژنها با آنتیبادیهای مربوط به آنها است.
واکنشهای آگلوتیناسیون برای شناسایی آنتیژنهای ذرهای استفاده میشوند که معمولاً به یک حامل متصل شدهاند. این حامل میتواند مصنوعی باشد، مانند ذرات لاتکس یا زغال، یا زیستی باشد، مانند سلولهای قرمز خون.
فرآیند آگلوتیناسیونی که شامل سلولهای قرمز خون است، همآگلوتیناسیون (Hemagglutination) نامیده میشود و فرآیندی که با سلولهای سفید خون انجام میشود، لوکوآگلوتیناسیون (Leukoagglutination) نامیده میشود.
این ذرات متصل شده سپس با سرم بیمار واکنش میدهند، که ممکن است حاوی آنتیبادی باشد یا نباشد.
نتیجه این آزمایش بر اساس مشاهده کلوخههای حاصل از تشکیل کمپلکس آنتیژن–آنتیبادی جمعآوری میشود.
حساسیت و دقت نتیجه به عوامل متعددی بستگی دارد، مانند مدت زمان انکوباسیون با آنتیبادی، مقدار و قدرت آنتیژن متصل شده به حامل، و شرایط آزمایش مانند pH و غلظت پروتئین.
کاربردهای آگلوتیناسیون و تکنیکهای پیشرفته در تشخیص
انواع مختلف آگلوتیناسیون در آزمایشهای تشخیصی استفاده میشوند که شامل آگلوتیناسیون لاتکس، تستهای فلوکولاسیون، آگلوتیناسیون مستقیم باکتریایی و همآگلوتیناسیون هستند.
از آنجایی که این فرآیند سریع و ساده است، این آزمایشهای تشخیصی نسبت به سایر آزمایشهای پیچیدهتر ترجیح داده میشوند.
آگلوتیناسیون برای شناسایی آنتیژنها در باکتریها به کار رفته است که در نهایت به تشخیص آن باکتریها کمک میکند.
یک تکنیک اصلاحشده و حساستر مرتبط با آگلوتیناسیون، آگلوتیناسیون-PCR است.
در این تکنیک، آنتیبادیها با آنتیژنهای متصل به DNA واکنش داده و آنها را آگلوتینه میکنند، که این امکان را فراهم میکند تا رشتههای DNA با آنتیبادیها لیگیت شوند.
سپس آگلوتیناسیون ایجاد شده برای تعیین مقدار رشتههای DNA با استفاده از q-PCR به کار میرود.
رسوبگذاری: از واکنشهای ایمنی تا شیمی تحلیلی

برای بررسی تفاوت آگلوتیناسیون و رسوبگذاری بیایید ابتدا مروری بر رسوب گذاری داشته باشیم.
رسوبگذاری (Precipitation) فرآیندی است که در آن آنتیژنهای محلول با آنتیبادیهای خاص خود در دمای بهینه و pH مناسب واکنش میدهند و در نتیجه یک رسوب نامحلول تشکیل میشود.
تعامل بین آنتیژن محلول و آنتیبادی منجر به تشکیل شبکهای نامحلول میشود که به شکل رسوب از محلول خارج میگردد.
فرآیند رسوبگذاری دارای برخی الزامات است که شامل والانسی (valency) هر دو مولکول آنتیژن و آنتیبادی میشود. برای وقوع رسوبگذاری، آنتیبادی باید دوانی (bivalent) باشد و آنتیژن باید یا دوانی یا چندانی (polyvalent) باشد.
رسوبگذاری در منطقه برابری (zone of equivalence) رخ میدهد، جایی که غلظت آنتیژن و آنتیبادی برابر است. در خارج از این منطقه، اگر غلظت آنتیژن یا آنتیبادی بیش از حد یا ناکافی باشد، رسوبگذاری اتفاق نمیافتد.
تکنیکهای ایمنیشناسی مانند ایمونودیفیوژن (immunodiffusion) و الکتروایمونودیفیوژن(electroimmunodiffusion) از اصول واکنشهای رسوبگذاری استفاده میکنند.
رسوبگذاری همچنین در شیمی تحلیلی برای شناسایی گروههای عاملی مختلف مواد شیمیایی به کار میرود.
اگر رسوب سبکتری تشکیل شود، فرآیند دیگری به نام فلوکولاسیون (flocculation) رخ میدهد. در فلوکولاسیون، رسوب به جای تهنشینی، به صورت شناور باقی میماند.
واکنشهای رسوبگذاری معمولاً روی سطوح نیمهجامد مانند محیط آگار یا رسانههای پشتیبانی غیرژلی مانند استات سلولز انجام میشوند.رسوب تشکیل شده در واکنش تا زمانی که نیروی گرانش کافی باعث تهنشینی آن به پایین سطح شود، در حالت معلق باقی میماند.
تفاوت گلوتیناسیون و رسوبگذاری

در جدول زیر به بررسی تفاوت آگلوتیناسیون و رسوبگذاری خواهیم پرداخت.
| معیار مقایسه | آگلوتیناسیون | رسوبگذاری |
| تعریف | آگلوتیناسیون فرآیند کلوخهشدن آنتیژنها با آنتیبادیهای مربوط به آنها است. | رسوبگذاری فرآیندی است که در آن آنتیژنهای محلول با آنتیبادی خاص خود در دمای بهینه و pH مناسب واکنش داده و رسوب نامحلول تشکیل میدهند. |
| اندازه آنتیژن | نسبتاً کوچکتر | نسبتاً بزرگتر |
| محلول بودن | آنتیژنهای نامحلول استفاده میشوند. | آنتیژنهای محلول استفاده میشوند. |
| حساسیت | واکنشهای آگلوتیناسیون حساستر از واکنشهای رسوبگذاری هستند. | واکنشهای رسوبگذاری حساسیت کمتری نسبت به آگلوتیناسیون دارند. |
| اصل واکنش | آگلوتیناسیون بر اساس تجمع ذرات (clumping) است. | رسوبگذاری بر اساس تشکیل شبکهها (lattice یا cross-linkage) است. |
| واکنشهای درگیر | شامل واکنشهای شیمیایی تشکیل کمپلکس | شامل واکنشهای شیمیایی بین یونها و مولکولهای نمک |
| محیط آزمایش | به ماتریکس ژل نیاز نیست. | به یک محیط مایع یا نیمهجامد نیاز است. |
| ترکیب حاصل | آگلوتیناسیون منجر به تشکیل کلوخهها (agglutinates) میشود. | رسوبگذاری منجر به تشکیل رسوبات (precipitates) میشود. |
| ماهیت کمپلکس تشکیل شده | آگلوتینها معمولاً به ته ظرف تهنشین میشوند. | رسوبات ممکن است معلق بمانند یا تهنشین شوند. در فلوکولاسیون، ذرات روی سطح محیط شناور میمانند. |
| ماهیت واکنشدهندهها | مولکولهای آغازین در آگلوتیناسیون ذرات هستند. | مولکولهای آغازین در رسوبگذاری یونها هستند. |
| نیازمندیها | واکنشهای آگلوتیناسیون سطحی هستند، بنابراین سطح آنتیژن باید برای اتصال آنتیبادی و تشکیل کلوخههای قابل مشاهده در دسترس باشد. | غلظت آنتیژن و آنتیبادی باید برابر باشد. هر تغییر در این توازن مانع تشکیل رسوبات میشود. |
| زمان واکنش | واکنشهای آگلوتیناسیون ممکن است از چند دقیقه تا چند ساعت طول بکشند. | واکنشهای رسوبگذاری ممکن است از چند ساعت تا چند روز طول بکشند. |
| ظاهر محصول نهایی | محصولات نهایی آگلوتیناسیون به صورت تجمعات بزرگ قابل مشاهده ظاهر میشوند. | محصولات نهایی رسوبگذاری به صورت رسوبات بزرگ و نامحلول قابل مشاهده ظاهر میشوند. |
| کاربردها | در تعیین گروه خونی | در آنالیز کمی و تشکیل رنگدانهها |
مثالهای آگلوتیناسیون: تست همآگلوتیناسیون
برای درک بهتر تفاوت آگلوتیناسیون و رسوبگذاری مثالی از هردو روش بررسی خواهیم کرد.
تست همآگلوتیناسیون (Haemagglutination Assay) یک تکنیک تشخیصی است که برای شناسایی ویروسها، باکتریها و آنتیبادیها به کار میرود.
آنتیژنهای موجود در ویروسها یا باکتریهای مختلف با گیرندههای اسید سیالیک (sialic acid) موجود روی سطح سلولهای قرمز خون واکنش میدهند و شبکهای از سلولهای قرمز و ذرات ویروسی ایجاد میکنند.
تشکیل این شبکهها به غلظت ویروسها یا باکتریها و سلولهای قرمز خون بستگی دارد.
وقتی غلظت آنتیژن خیلی کم باشد، سلولهای قرمز در شبکهها قرار نمیگیرند و به جای آن در ته ظرف تهنشین میشوند.
همآگلوتیناسیون بر اساس همان اصلی عمل میکند که ویروسها در طول عفونت از آن استفاده میکنند.
یک نمونه کنترل در یکی از چاهکها قرار داده میشود تا غلظت آنتیژن موجود در نمونه با آن مقایسه شود.
براساس میزان آگلوتیناسیون شکل گرفته در چاهک، میتوان غلظت آنتیژن را تعیین کرد. سپس با استفاده از این غلظت، میتوان مقدار ارگانیسم موجود در نمونه را مشخص نمود.
مثالهای رسوبگذاری: تست رسوب ایمونودیفیوژن
ایمونودیفیوژن (Immunodiffusion Precipitation Test) یک تکنیک ایمنیشناسی است که برای شناسایی و تعیین کمیت آنتیبادیها و آنتیژنها به کار میرود، که اغلب شامل ایمونوگلوبولینها و آنتیژنهای هستهای هستند.
در این تکنیک، آنتیژن و آنتیبادی به صورت همزمان در دو چاهک مجاور قرار داده میشوند.
همزمان با انتشار آنتیژن و آنتیبادی به سمت یکدیگر، رسوبات به شکل خطوط قابل مشاهده ایجاد میشوند، زیرا آنتیژن و آنتیبادی با هم واکنش میدهند.
همچنین امکان مقایسه غلظت آنتیژنهای مختلف با قرار دادن چند آنتیژن در چند چاهک وجود دارد.
بر اساس شکلگیری خطوط رسوب، میتوان وجود آنتیژنهای مختلف و به تبع آن وجود ویروسها یا باکتریها را شناسایی کرد.
جمعبندی
واکنشهای آگلوتیناسیون و رسوبگذاری دو ابزار قدرتمند در زمینه تشخیصهای ایمنیشناسی و آزمایشگاهی هستند که هر کدام مکانیزمها، کاربردها و شرایط خاص خود را دارند. آگلوتیناسیون فرآیندی سریع و حساس است که با تجمع ذرات نامحلول آنتیژن و آنتیبادی، کلوخههایی قابل مشاهده ایجاد میکند و به ویژه در تعیین گروههای خونی و شناسایی سریع عوامل بیماریزا کاربرد دارد. در مقابل، رسوبگذاری واکنشی است که آنتیژنهای محلول را با آنتیبادیهای خاص ترکیب کرده و رسوبات نامحلول ایجاد میکند، که در آن غلظتها و شرایط محیطی نقش کلیدی در موفقیت واکنش دارند و برای شناسایی و تعیین کمیت آنتیژنها و آنتیبادیها استفاده میشود.
در نهایت، شناخت دقیق تفاوت آگلوتیناسیون و رسوبگذاری نه تنها در آزمایشگاههای تشخیص بالینی اهمیت دارد. بلکه پایهای برای توسعه تکنیکهای پیشرفتهتر مانند آگلوتیناسیون PCR و سایر روشهای نوین تشخیصی فراهم میآورد و به بهبود دقت و سرعت تشخیص بیماریها کمک میکند.






